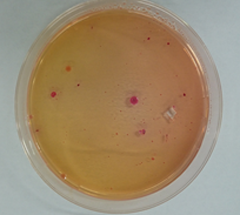

| TOP > 気になる「水」「食」「大気」のはなし > ふき取り検査 | ||||||||||||
| ふき取り検査 | ||||||||||||
|
目に見えない菌を数値化する 近年、食中毒事故の件数は年間およそ1000件にもおよび、その中で食中毒の患者は2万人を超えているといわれています。食中毒の主な原因は、目では確認することのできない細菌やウイルスです。いくらきれいにしているからといっても、目に見えないので、もしかしたら食中毒菌や細菌に汚染されているかもしれません。目に見えない菌を数値化し把握することで、衛生状態がわかり食中毒の予防に繋がります。 ふき取り検査とは? ふき取り検査では、食品工場や厨房の衛生状況を把握することができます。 食品工場や、厨房のまな板や包丁などの調理器具、ドアノブや冷蔵庫内、調理台などの器具や設備、従業員の手指など(検査対象は下記参照)をふき取り用綿棒を用いてサンプリング調査を行います。サンプルを細菌検査することにより、厨房施設内の衛生状況を明確に把握でき、汚染防止に役立ちます。 ◆検査対象 1.食品そのもの 2.食品が直接触れる部分や面(包丁、まな板、調理機器、器具、コンベアなど) 3.人の手が触れる場所(冷蔵庫の取手やドアノブ、調理器具の握るところ、機械のスイッチなど) 4.その他の場所(壁、作業台、機器の周りや上部など) 5.食品取扱従事者の手指 検査は、100cm2(10cm×10cm)の定面積を綿棒でふき取って適宜希釈し、培地と混釈して細菌数を測定する方法と、検査する物体の表面に培地を接触させて細菌を培地表面に発育させ、細菌数(コロニー)を測定する方法があります。 ◆主な検査項目 主な検査項目には一般細菌、大腸菌群、黄色ブドウ球菌があります。左記の写真は、弊社で実際に検出されたものです。 一般細菌 特定の細菌を指すのではなく、いわゆる雑菌のことを指します。病原性のあるものは少ないのですが、汚れの指標としています。 大腸菌群 加熱処理工程のある商品から検出された場合、加熱工程が不十分であったか、加熱処理工程後の取り扱いが悪くて2次汚染したかを示します。また、自然界にも広く分布しています。 黄色ブドウ球菌 ヒトや動物の皮膚に存在する常在菌で、食品中で増殖すると毒素をつくります。この毒素は耐熱性のため、加熱しても食品中に残るので食中毒が起こります。 ふき取り検査を行った際に菌が検出された場合、「しまった!」と思うのではなく、どこに重点をおいて清掃や消毒を行えば食中毒を予防することができるのかを知ることが大切です。 法律では、食品工場における基準および規制は設けられていません。そのため、施設内の衛生管理状況を把握するということは、食中毒を出さないようにするということにつながっていくのではないでしょうか?
※本記事の内容は掲載当時の情報に基づいており、現在の法令や基準値とは異なる場合がございます。
|
||||||||||||
|
||||||||||||